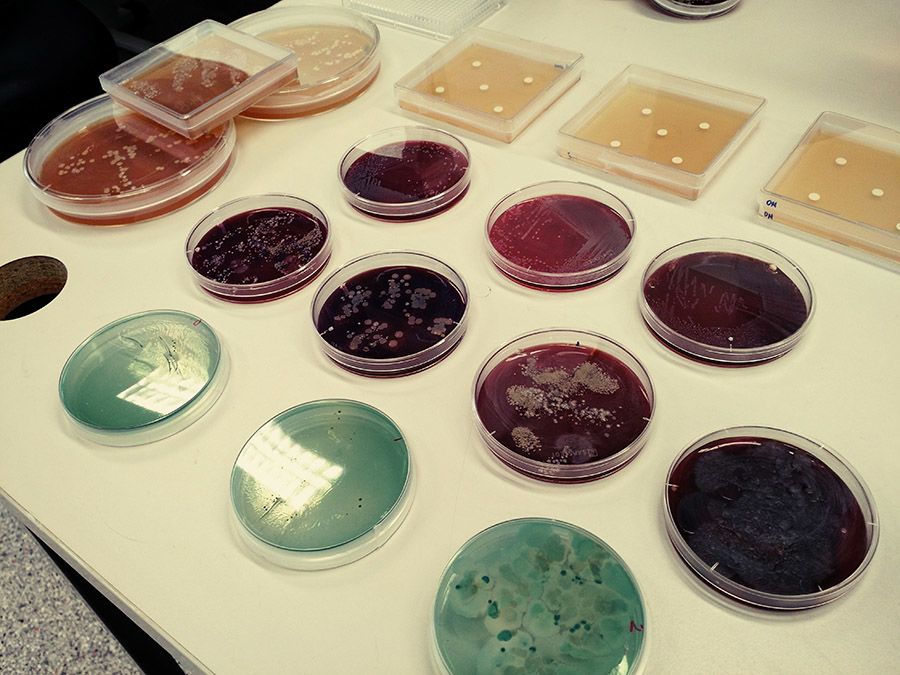

Help us discover the unknown in antibiotics

Crowdsourcing a solution to the superbug crisis
Resistance to antibiotics has reached crisis point globally. Deaths due to drug-resistant diseases already number at least 700,000 per year worldwide. The antibiotics humans and animals take to treat or protect against infection are being increasingly rendered inadequate because bacteria are developing resistance. These resistant bacteria spread by personal contact or consumption of contaminated meat, vegetables and water, and they can also transfer resistance to non-related bacteria, exacerbating the problem.
Unfortunately, the upswing in drug-resistant bacteria has occurred at the same time as a decline in antibiotic research by pharmaceutical companies. Added to these factors is a surge in the number of international travellers, increasing the chances for people to be infected in countries where resistant bacteria are prevalent, sometimes with fatal consequences.

Antibiotic-resistant bacteria are spreading around the world.
Antibiotic-resistant bacteria are spreading around the world.
In Australia, the cost incurred by hospital-related infections is $942 million per year, while the United States spends $35 billion. The situation is not just critical economically and socially: superbugs pose an enormous threat to our very existence, according the World Health Organisation.
“There is no time to wait. Unless the world acts urgently, antimicrobial resistance will have disastrous impact within a generation.” No Time to Wait: Securing the future from drug-resistant infections – Report to the Secretary-General of the United Nations, April 2019
The report shared the sobering statistic that deaths from drug-resistant infections could rise to 10 million deaths per year globally by 2050 if no action is taken.
In a bid to avert this scenario, we’re crowdsourcing a solution, tapping into researchers the world over to discover the next generation of antibiotics. We’ve partnered with the Wellcome Trust and other groups to establish CO-ADD: The Community for Open Antimicrobial Drug Discovery. This not-for-profit initiative has been operating since 2015 and screen compounds for antimicrobial activity, free of charge to academic researchers globally.
CO-ADD is screening compounds from around the world for antimicrobial activity.
CO-ADD is screening compounds from around the world for antimicrobial activity.
There are currently 36 million compounds registered in the Chemical Abstracts Service registry (CAS) whose chemical properties remain unknown, leaving a plethora of potential antibiotic ‘superheros’ – out there, undiscovered!
After our global shout-out, CO-ADD received 200,000 compounds in response, with 500 researchers at 200 institutes representing 45 countries sending samples in to be screened. CO-ADD is a fantastic opportunity to investigate what this mysterious reservoir of novel chemical compounds can offer in the world’s race to defeat superbugs.
As a result of enthusiastic support, CO-ADD has helped identify more than 1,500 potential new antibiotics that could help stop superbugs.
